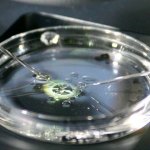
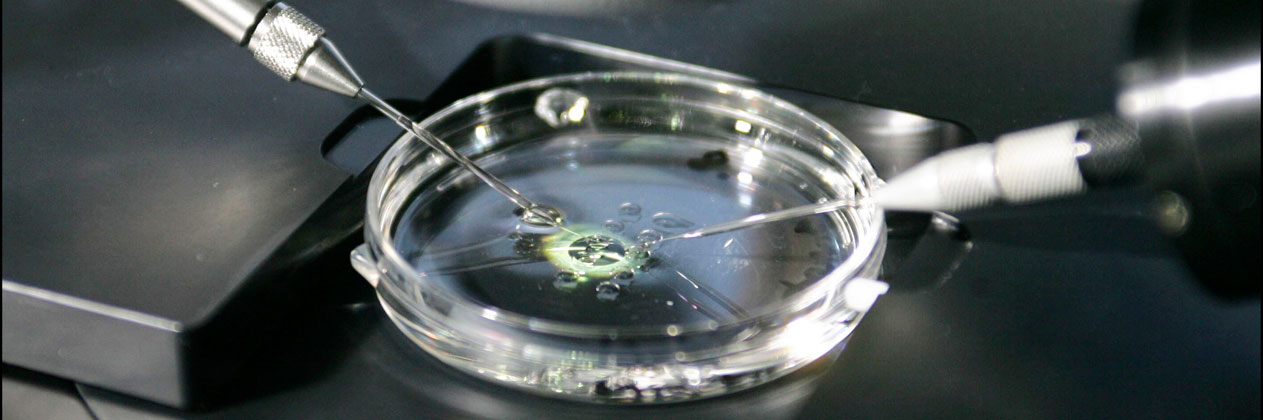

Todos queremos que nuestros hijos sean felices, que estén sanos, que tengan una vida plena llena de alegrías y posibilidades, que tengan opciones y que se puedan preparar para desarrollarse profesionalmente en lo que más les realice como personas.
Eso así, en términos generales es lo que queremos yo diría que todos los padres y madres del mundo para nuestras hijas e hijos.
Y algunos lo tienen, pueden conseguirlo. Otros no, otros se quedan por el camino, otros pueden alcanzar algunos de esos sueños y pueden ser felices pero quizás no han tenido todas esas opciones y posibilidades que como madres y padres nos habría encantado que tuvieran.

La inteligencia es una de ellas, no todo el mundo está preparado intelectualmente para estudiar una determinada disciplina por mucho que quiera o le guste, como no todo el mundo tiene oído para cantar por más que disfrute haciéndolo. Es la realidad.
A veces, es verdad que a la realidad, le llega el mercado y le hace un adelantamiento por la derecha, sin avisar.
Me pone cuarto y mitad más de inteligencia para mi hija
El 40% de los estadounidenses que participaron en una encuesta publicada hace unas semanas por la revista científica Science, reconocieron que ellos ante un tratamiento de fertilidad en el que les plantearan la posibilidad de evaluar cuál de sus embriones tendría más posibilidades de entrar en alguna de las mejores universidades del país, dirían que sí. Harían ese cribado. Escogerían a los embriones más listos en detrimento de todos los demás.
Por contra y de forma unánime, la comunidad científica es más de echarse las manos a la cabeza ante esta posibilidad de selección embrionaria.
Y claro, si un 40% de los encuestados lo haría es porque hay demanda entre la población aunque los científicos estén convencidos de que se trata de una idea terrible.
Y si hay demanda hay oferta, más pronto que tarde. De hecho en Estados Unidos ya hay una empresa que comercializa sus pruebas de predicción embrionaria aunque hasta ahora van más por el campo de la salud ofreciendo puntuaciones sobre la probabilidad de que se desarrollen enfermedades comunes, diabetes o esquizofrenia a lo largo de su vida.
Poderoso caballero es Don Dinero
Numerosas voces han expresado su preocupación sobre las pruebas predictivas de embriones, sobre su ética, su eficacia, si son o no reales.
En 2022, la Sociedad Europea de Genética Humana las calificó de poco éticas y sugirió prohibirlas directamente hasta que se desarrolle una regulación sobre ellas.
Pero vamos un paso más allá a la vista de lo que señalan científicos de distintas áreas. Si estas pruebas son reales, si se ponen en el mercado, si el padre y la madre están de acuerdo en que quieren un embrión que vaya a ser el nuevo Einstein del futuro, tendrán que poder pagarlo.
Es decir, estamos hablando de que las desigualdades sociales que ya existen serán aún mayores porque solo las grandes fortunas podrán asegurarse una descendencia más lista, más inteligente, más sana, más de todo.
Nos estamos acercando a un mundo que parece una película de ciencia ficción pero no tenemos claro si tendrá un final feliz.
TAMBIÉN LEE: